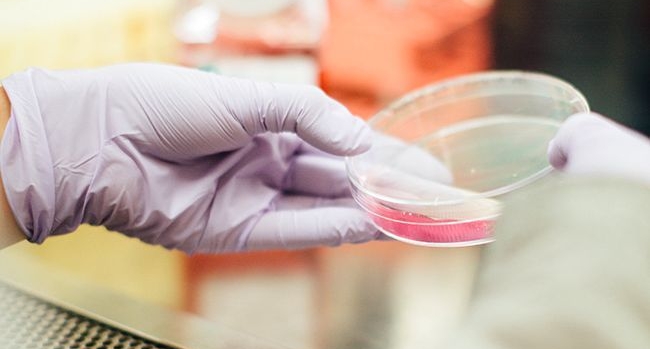

При какой температуре гибнет коронавирус: ученые поразили открытием
Фото: unsplash.com/drew-hays
Исследователи провели эксперимент, при котором штамм с коронавирусом поместили в пробирку с биоматериалом.
Два образца с вирусом и биоматериалом подогревали до 60 градусов, тепло сохраняли в течение 60 минут. После этой процедуры коронавирус не выжил и потерял свою силу. Это произошло при температуре 92 градуса Цельсия через 15 минут.
Отметим, что обычно лаборатории дезинфицируют при температуре 60 градусов.
Этот опыт дал основания полагать, что для образцов с высоким содержанием вируса этого может не хватить, и выразили надежду, что результаты исследования помогут выбрать наиболее подходящий способ дезактивации коронавируса.
Кстати, главный эпидемиолог Швеции Андерс Тегнелл заявил, что коронавирус никуда не исчезнет, а будет вызывать ежегодные эпидемии, как сезонный грипп. Он признал, что власти Швеции потерпели неудачу в области ухода за пожилыми людьми, поскольку более половины смертей в стране произошли в домах престарелых.
Заметили ошибку? Пожалуйста, выделите её и нажмите Ctrl+Enter







